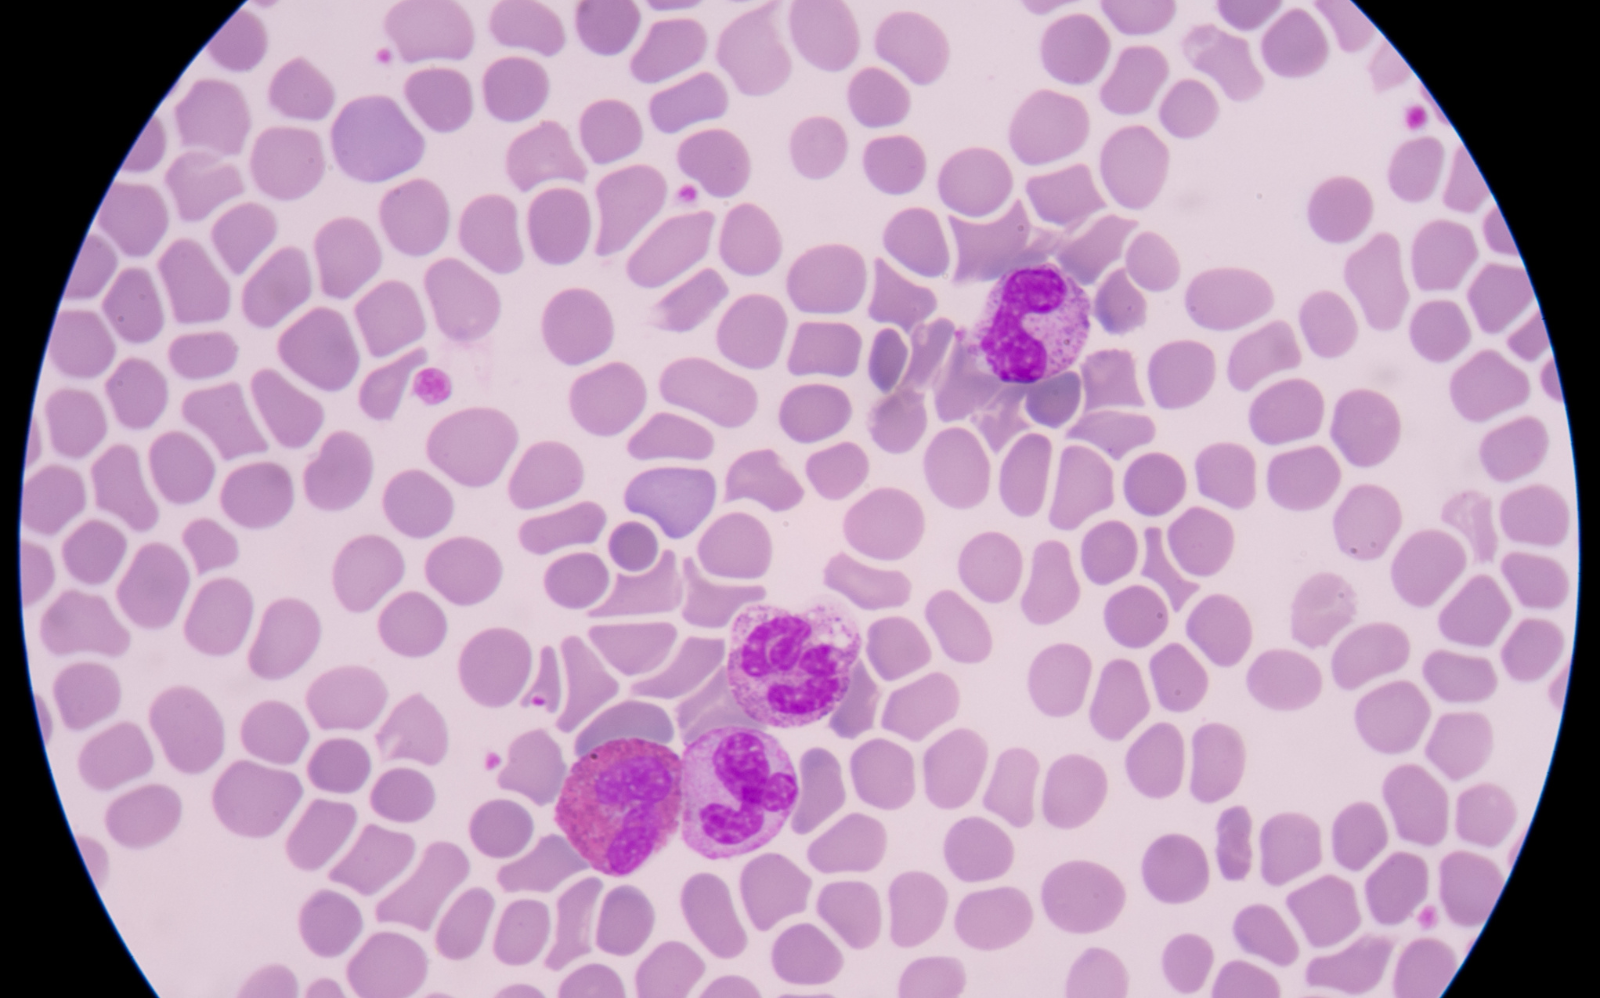
septicémie bactérie

Septicémie : l’infection dans le sang
Toute bactérie a besoin d’une « porte d’entrée » pour infecter un organisme. Il s’agit selon les cas d’une plaie qui s’infecte, d’un furoncle, d’un germe qui colonise les bronches ou les poumons...
Si l’infection reste en général localisée et confinée au premier site, les bactéries peuvent parfois passer dans le sang et être charriées par la circulation sanguine dans tout l’organisme. C’est ce qu’on appelle une septicémie (ou bactériémie). Elle survient dans 15 à 25 % des infections graves et peut avoir des conséquences importantes, comme le choc septique.
Les symptômes de la septicémie
Une septicémie peut tout à fait rester asymptomatique. Dans la plupart des cas, elle provoque toutefois un syndrome de réponse inflammatoire systémique (SRIS). Ce syndrome est dû à une réaction « excessive » du système immunitaire face à l’infection.
Il se manifeste par :
-
de la fièvre (plus de 38° C) ou de l’hypothermie (moins de 36° C) ;
-
une augmentation du rythme cardiaque (plus de 90 battements par minute) ;
-
une augmentation de la fréquence respiratoire (plus de 20 cycles par minute) ;
-
une augmentation du nombre de globules blancs dans le sang (plus de 12.000 par mm3).
Lorsque la septicémie est associée à un tel syndrome, on parle de sepsis. Il s’agit d’un cas d’urgence qui évolue souvent vers des états plus graves.
Sepsis : différents stades de gravité
On distingue 3 formes de sepsis en fonction de leur gravité : la sepsis simple, la sepsis grave et le choc septique.
-
La sepsis grave survient lorsque certains organes montrent par exemple des signes de défaillance : apparition de troubles du rythme cardiaque, arrêt respiratoire, altération de l’état de conscience, atteinte hépatique...
Un marqueur présent dans le sang (le lactate) montre également, lorsqu’il est élevé, le degré de gravité de la sepsis.
-
Lorsqu’à cette sepsis grave s’ajoute une chute importante de la tension artérielle (tension artérielle systolique inférieure à 90 mmHg ou diastolique inférieure à 40 mmHg) ou une atteinte du cœur, c’est le choc septique. Le cœur ne parvient alors plus à faire circuler le sang efficacement dans l’organisme, et donc à assurer le transport de l’oxygène et des nutriments vers les tissus. Un choc septique mène au décès dans un cas sur deux.
Septicémie : des séquelles à long terme
Dans certains cas, la septicémie peut propager l’infection à d’autres organes.
Le manque d’oxygène consécutif aux problèmes de circulation sanguine générés par le choc septique peut également occasionner une souffrance de certains organes – puisque ceux-ci ne sont plus correctement irrigués – et laisser des séquelles à long terme au niveau des reins, du cœur, du foie...
Le diagnostic de septicémie
Un examen clinique complet doit permettre au médecin de trouver l’origine de l’infection, la « porte d’entrée » par laquelle est entrée la bactérie, et ce afin de pouvoir choisir le traitement le plus approprié. On ne soigne pas une cystite comme on soigne une pneumonie.
Des examens d’imagerie peuvent également permettre de repérer le foyer infectieux : radiographie du thorax et des poumons, échographie cardiaque, échographie abdominale...
Des prélèvements sanguins permettent de confirmer la présence d’une infection si le taux de globule blanc est important (signe que le système immunitaire est en action). Ils peuvent également permettre de confirmer la présence de bactéries dans le sang, et donc la septicémie.
D’autres prélèvements peuvent également s’avérer nécessaires en fonction du type d’infection soupçonnée, une ponction lombaire par exemple si l’on soupçonne une méningite.
Septicémie : quel traitement ?
En cas de septicémie, plus le traitement est rapide, plus les chances de guérison sont grandes. Dans un premier temps, et en attendant d’avoir pu confirmer l’origine de l’infection, un traitement antibiotique à large spectre – qui est efficace contre un nombre important de souches bactériennes – est donc administré.
Lorsque les médecins ont la confirmation au bout de quelques heures ou de quelques jours du foyer infectieux, ils peuvent adapter le traitement. Ils choisissent alors un antibiotique plus efficace face à la bactérie responsable de l’infection.
À lire aussi
Seniors : méfiez-vous de la grippe
Antibiotiques : en prendre ou pas ?
Source
Interview du Pr Claude Martin, Chef du service d’anesthésie réanimation à l’Hôpital Nord (Assistance Publique des Hôpitaux de Marseille).